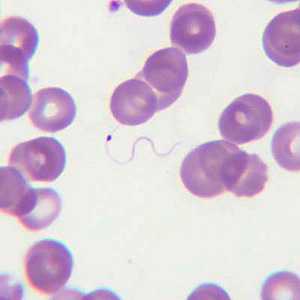
Case205

Case #205 - June, 2007
A 30-year-old man from Sudan had fever and chills. He was also mildly jaundiced. He went to his physician who ordered a blood smear examination. Smears were made and stained with Leishman’s stain. Figures A-E were captured from the thin smears. What is your diagnosis? Based on what criteria?

Figure A

Figure B

Figure C
Figure D

Figure E
Case Answer
This was a case of malaria caused by Plasmodium vivax. Diagnostic features included:
- amoeboid trophozoites (Figure A). The infected red blood cells (RBCs) were enlarged 1.5×, and in one, there was a hint of Schϋffner’s stippling.
- a slightly-enlarged gametocyte (Figure B).
- a schizont with approximately 15 or 16 merozoites (Figure C).
- microgametes, a result of exflaggelation of male gametocytes (microgametocytes). This can happen when the blood sits for a while at room temperature before the smears are made. They should not be mistaken for trypanosomes, which are much broader and have a nucleus and a kinetoplast.
More on: Malaria
This case and images were kindly contributed by Dr. CSBR Prasad, Vindhya Clinic and Diagnostic Lab, India.
Images presented in the monthly case studies are from specimens submitted for diagnosis or archiving. On rare occasions, clinical histories given may be partly fictitious.
DPDx is an education resource designed for health professionals and laboratory scientists. For an overview including prevention and control visit www.cdc.gov/parasites/.
- Page last reviewed: August 24, 2016
- Page last updated: August 24, 2016
- Content source:
- Global Health – Division of Parasitic Diseases and Malaria
- Notice: Linking to a non-federal site does not constitute an endorsement by HHS, CDC or any of its employees of the sponsors or the information and products presented on the site.
- Maintained By:


 ShareCompartir
ShareCompartir